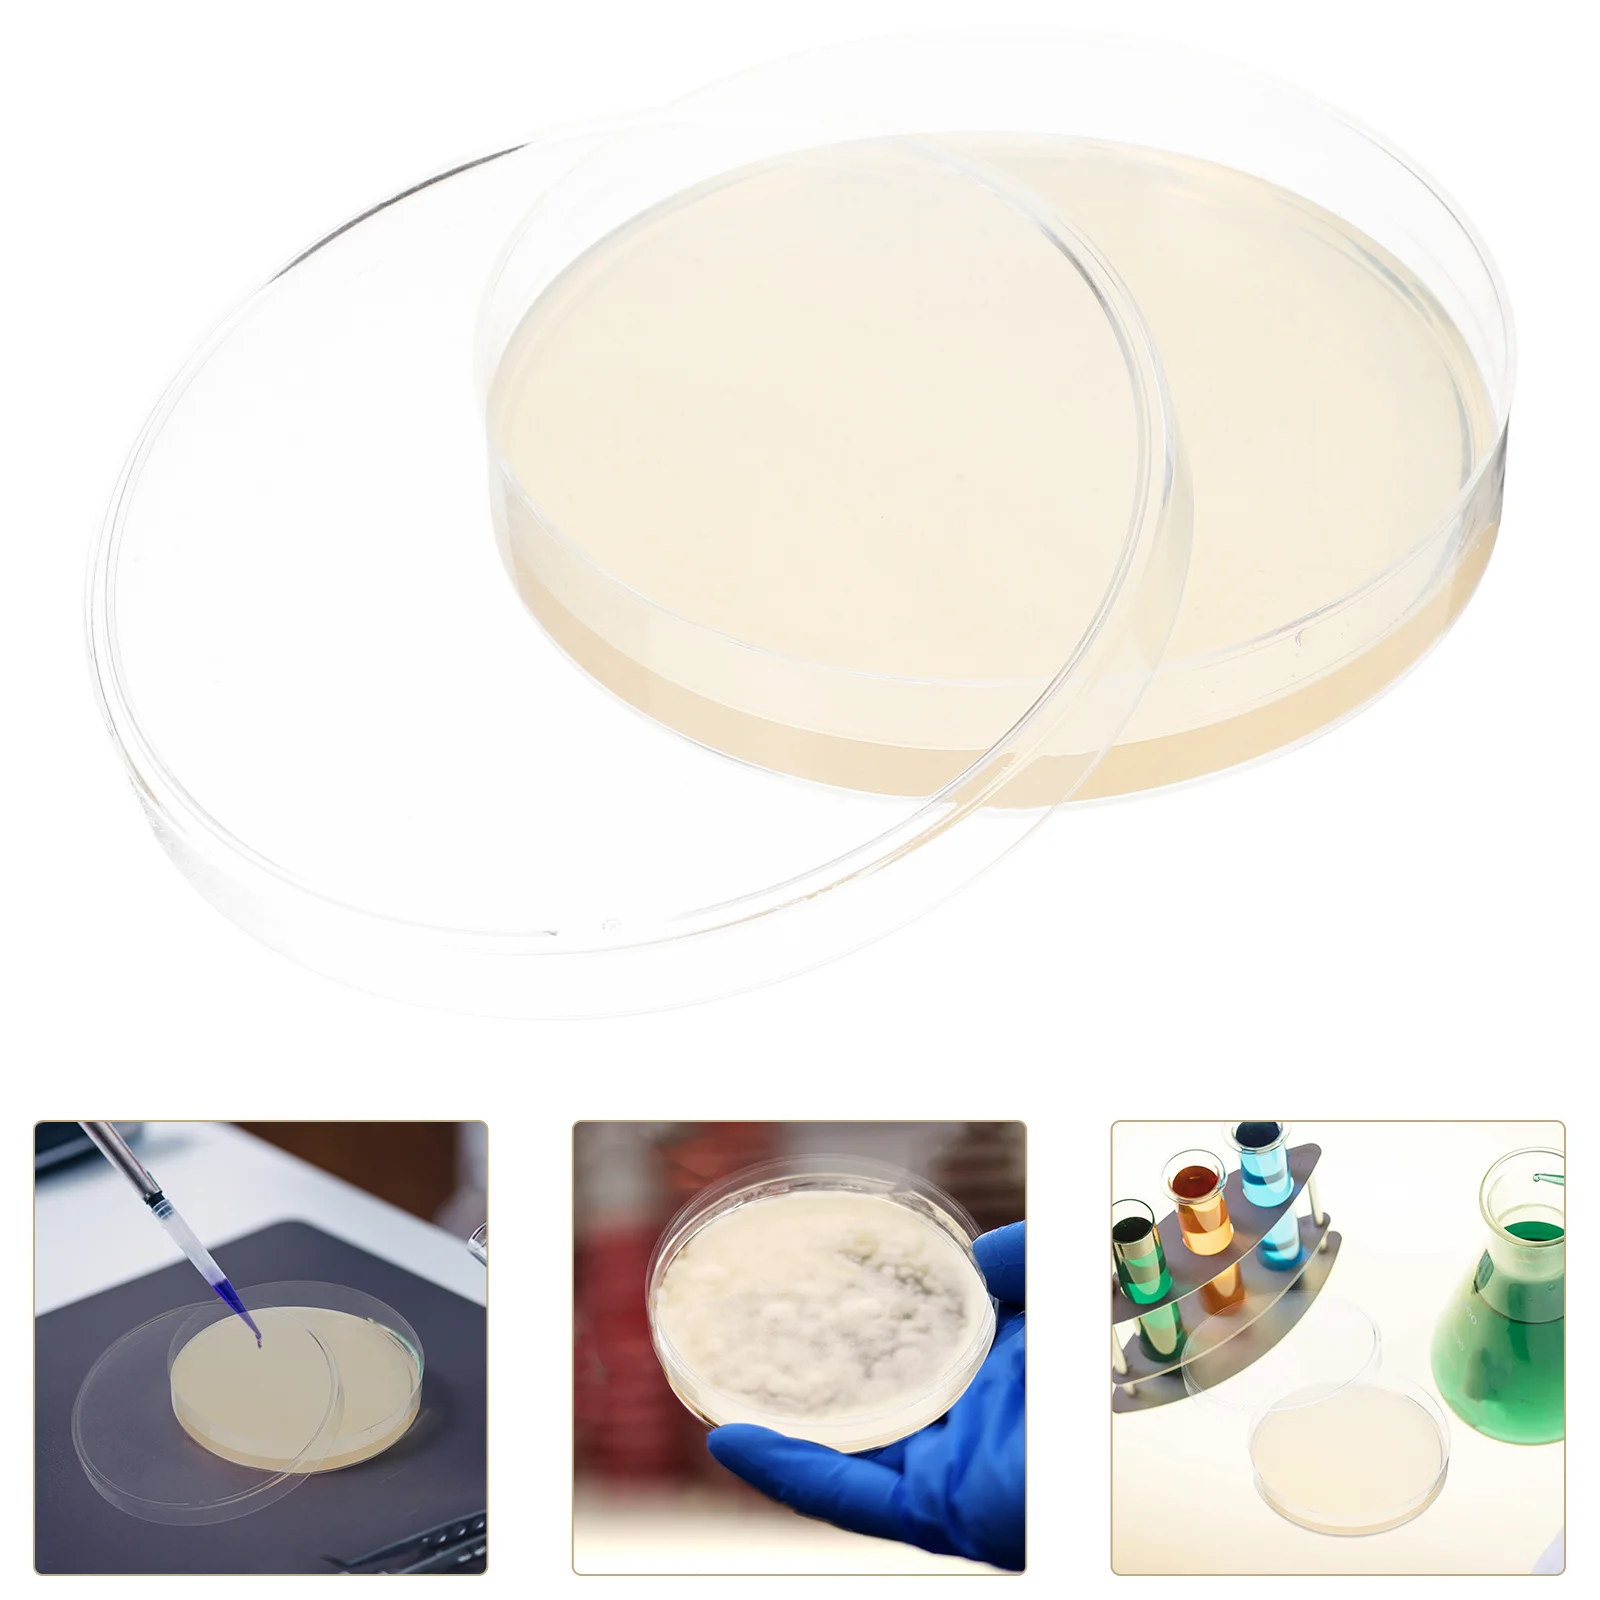
thumb

10 шт., игрушечные агары, среднее биологическое оборудование для определения уровня глюкозы
График изменения цены & курс обмена валют
Пользователи также просматривали

$25.02
ArtzFolio Printed UV-Resistant Anti-Bacterial Creative Triangles Peel & Stick Wallpaper, Multi
myntra.com
$56.47
Материнская плата Zillion HM65 D3K2 Mini ITX PGA 988 DDR3 с поддержкой процессора Intel Core i3/i5/i7 Pentium Celeron для игрового ПК, новинка
aliexpress.ru
$5.05
Японское аниме Yu-Gi-Oh! Самодельная Коллекционная открытка «сделай сам» с красными глазами и черным драконом, игрушка, Рождественский подарок на день рождения
aliexpress.ru
$493.51
Комплект для преобразования автомобильного сиденья под заказ для toyot LC200 LC150 FJ150 RAV 4
aliexpress.ru
$28.16
Подкладка для домашних животных, розовые красные виниловые оберточные листы, глянцевая прозрачная виниловая углеволоконная пленка для автомобиля
aliexpress.ru
$493.17
Ящик для инструментов на колесиках для хранения 258 шт., набор автоматических инструментов
aliexpress.ru
$14.39
For Kia NEW K3 2019 2020 2021 Spoiler High Quality ABS Plastic Primer Color Rear Window Roof Spoiler Wing Body Kit Accessories
aliexpress.ru
$10.63
HQIX for Panasoinc DMC-TS5 TS7 TF5 TZ41 TZ40 ZS50 ZS30 ZS45 ZS40 ZS35 Camera DMW-BCM13E Dual Charger Battery
aliexpress.ru
$0.68
Separated Type Flush Toilet Water Tank Push Buttons Rods 12x10x5.5cm For Home Hotel Single Button Toilet Drain Control Switch
aliexpress.ru
$1,758.58
Smart Drop Shipping 2 Wheel One Person 2000W Electric Golf Scooter with Golf Bag Holder
aliexpress.ru
$1,311.11
Повседневные обеденные столы в скандинавском стиле, круглые уникальные столовые приставки, обеденный стол, кофейный кухонный обеденный стол, наборы садовой мебели
aliexpress.ru
$112.99
new for DJI phantom4 Pro/4 for phantom 4 advanced 15.2V 5870mAh High Energy Intelligent Spare Flight LiPo 4S Battery
aliexpress.ru
$0.19
1pcs M14 Electric Drill Adapter Angle Grinder Connecting Rod Hexagon Rod Conversion Bar Chuck Connector Electric Tools
aliexpress.ru
$240.92
Reusable Service Plates Food Bone China Kitchen Modern Dinner Plate Ceramic Trinket Tencere Setleri Dining Appliance MZY
aliexpress.com
$8.49
Plant Support Ring Long-lasting Reusable Convenient Installation Plant Cage Holder Plants Fixing Rod Bonsai Tool Plant Stakes
aliexpress.com
$12.70
Outdoor Camping Storage Bag Camping Meal Bag Large Storages Lamp Tableware Bags Campings Tool Picnic Camp Travel Basg
aliexpress.com
$5.90
Женские летние шлепанцы, новый дизайн 2022, пикантные пляжные сандалии с цепочкой, для улицы, женские сланцы
aliexpress.com
$38.99
LCD Motorcycle TPMS with Time Display Tyre Tire Pressure Monitoring System, 501 Original
cesdeals.com
$5.09
2Pcs/set Lion Dance Panda Chinese New Year Door Pendant Spring Festival Door Decoration Unisex
joom.ru
$75.09
all black chain triumphal bag for women's 2023 new junior high underarm bag one shoulder handbag 70% clearance outlet sale
dhgate.com
$7.15
Magnetic Cabinet Lock Key Replacement - Super Magnet For Most Brand Children'S Cabinets And Drawer Locks, Keychain 2 Package Key
aliexpress.com
$10.39
Sports Short Fitness Women Summer Yoga Shorts High Waist Push-up Five Points Running Fitness Yoga Short Pants Yoga Shorts Sport
aliexpress.com
$22.50
TSDTF Daily Willie Nelson Print High-top Flat Canvas Shoes Fashion Sneakers Plus
aliexpress.com